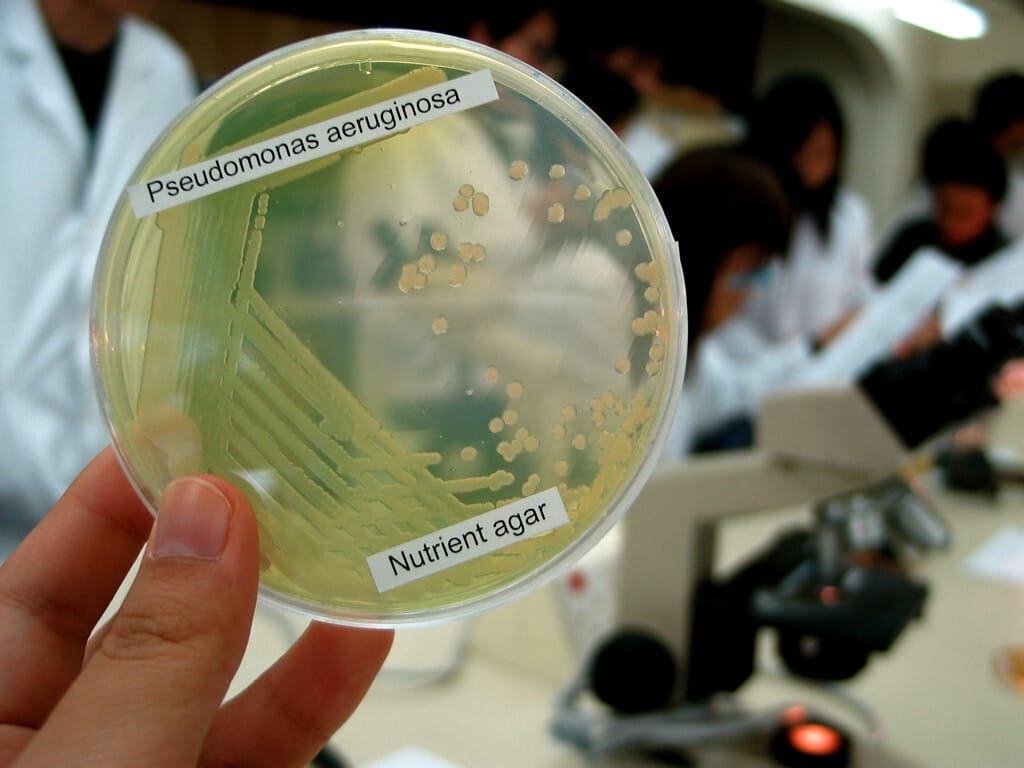

녹농균 감염 (Pseudomonas aeruginosa infection)
녹농균 (Pseudomonas aeruginosa)은 항생제 내성이 강한 그람음성 간균으로, 주로 면역저하자나 병원 환경에서 기회감염 형태로 발생합니다.
병원성은 낮지만, 일단 감염 시 빠르게 퍼지고 항생제 저항성이 강해 치료가 까다롭습니다.

| 녹농균 감염 (Pseudomonas aeruginosa infection) |
| 🟩 운동성을 가진 그람음성 간균이며, 습한 환경과 병원 환경에서 흔히 발견됩니다. |
원인
건강한 사람에겐 잘 감염되지 않지만, 면역저하자나 중환자실 환자에게서 기회감염 형태로 흔하게 발생합니다.
| 주요 원인 |
| 🔴 면역저하 상태 |
| 암 치료, 장기이식, 스테로이드 사용 등으로 인한 기회감염에서 잘 발생합니다. |
| 🔴 습한 환경 |
| 욕조, 호흡기 기기, 카테터 등 병원 환경에서 흔히 존재하며 감염을 일으킬 수 있습니다. |
임상양상
녹농균 감염은 감염 부위에 따라 매우 다양한 양상을 보이지만, 특정한 분비물 색깔과 냄새가 공통된 단서로 작용합니다.
특징적인 삼출물과 냄새는 녹농균 감염을 의심할 수 있는 가장 중요한 단서입니다.
| 공통적인 증상 및 징후 |
| 🟩 녹색 삼출물(greenish discharge) |
| 녹농균의 pyocyanin, pyoverdin 색소로 인해 분비물이 청록색 또는 황녹색을 띱니다. |
| 🟩 포도주 , 과일 같은 냄새? (sweet odor) |
| 감염 부위에서 포도주나 과일 같은 냄새가 납니다. 녹농균 고유의 휘발성 대사산물 때문입니다. |
| 🟩 항생제 치료에 잘 반응하지 않음 |
| 녹농균은 자연적인 내성 기전과 약제 펌프를 보유하고 있어 치료에 어려움이 많습니다. |
감염 부위별 임상양상
감염된 부위에 따라 증상이 뚜렷하게 달라지며, 중증으로 진행 시 전신 패혈증으로 이어질 수 있습니다.
| 감염 부위별 증상 |
| 🟦 외이도염 |
| 통증, 가려움, 청록색 고름 배출이 있으며, 고령자·당뇨병 환자에서는 악성 외이도염으로 진행 가능 |
| 🟦 세균성 각막염 |
| 콘택트렌즈 장기 착용 시 발생. 격심한 통증, 시력 저하, 녹색 눈곱 배출. 치료 지연 시 실명 위험. |
| 🟦 폐렴 (병원성/기회감염) |
| 기침, 호흡곤란, 녹색 가래. 인공호흡기 관련 폐렴(VAP)에서 가장 흔한 원인균 중 하나. |
| 🟦 화상 부위 감염 |
| 화상 부위에서 청록색 진물, 궤양, 감염이 깊게 침범하며 패혈증으로 빠르게 진행 가능. |
| 🟦 요로감염 |
| 도뇨관 삽입 환자에서 발생. 녹색 혼탁뇨, 특유의 악취, 감염 지속. |
| 🟦 피부/연조직 감염 |
| 수술 부위, 욕창, 카테터 부위 감염. 농양 형성 및 궤사 가능. |
| 🟦 패혈증 및 ecthyma gangrenosum |
| 면역저하자에서 발생. 혈류감염으로 진행하며, 특징적인 괴사성 피부 병변이 나타남. |




진단
배양 검사를 통해 녹색 삼출물(greenish discharge)이 특징적으로 관찰되며, 특유의 향(포도주 냄새)이 나는 경우도 있습니다.
| 진단 방법 |
| 🔵 배양 검사 |
| 녹색의 pyosyanin 색소를 띤 삼출물이 배양상 확인되며, 선택 배지에서 잘 자랍니다. |
| 🔵 항생제 감수성 검사 |
| 항생제 내성이 흔하므로 감수성 검사를 통해 적절한 약제를 선택합니다. |
치료
- 항녹농균 페니실린: Piperacillin
- 카바페넴: Meropenem, Imipenem, Doripenem
- 세팔로스포린 (4세대 이상): Ceftazidime (3세대), Cefepime (4세대)
- 플루로퀴놀론: Ciprofloxacin > Levofloxacin
- 아미노글리코사이드: Amikacin > Gentamicin, Tobramycin
- 폴리믹신계: Colistin, Polymyxin B
- 베타락탐/베타락타메이스 억제제 복합제
- Ceftazidime/Avibactam
- Ceftolozane/Tazobactam
- Piperacillin/Tazobactam
– 녹농균은 항생제 내성률이 빠르게 증가하고 있으므로, 감수성 검사 결과에 따라 선택해야 합니다.
– 단독 사용보다는 병용요법(특히 중증 감염 시)이 추천되며, β-lactam + aminoglycoside 또는 fluoroquinolone 조합이 대표적입니다.
– Ceftazidime, Cefepime, Meropenem 등이 녹농균 치료의 1차 약제로 자주 사용됩니다.
녹농균은 외막이 두껍고 항생제 내성기전이 다양하여, 선택적으로 활성을 가지는 항생제를 사용하는 것이 중요합니다.
| 녹농균에 항균 작용을 보이는 항생제 |
| 💊 Piperacillin-tazobactam (피페라실린-타조박탐) |
| 광범위 페니실린계 항생제이며, β-lactamase 억제제(tazobactam)를 포함하여 안정성이 높음. 녹농균에 대해 광범위하게 사용됩니다. |
| 💊 Ceftazidime (세프타지딤) |
| 3세대 세팔로스포린 중 녹농균에 대해 효과 있는 대표적인 약물입니다. CNS 침투가 가능하여 수막염에도 사용됩니다. |
| 💊 Cefepime (세페핌) |
| 4세대 세팔로스포린으로, ceftazidime보다 β-lactamase에 더 안정적이며 녹농균에 대해 우수한 활성을 가집니다. |
| 💊 Aztreonam (아즈트레오남) |
| 단일 β-lactam인 모노박탐(monobactam) 계열로, 녹농균에 특화되어 있으나 그람양성균에는 효과가 없습니다. * 페니실린 알레르기 환자에 사용 가능. |
| 💊 Meropenem, Imipenem, Doripenem (카바페넴계) |
| 광범위 항균 스펙트럼을 가지며, ESBL 생성 균주 및 녹농균에 우수한 활성을 보입니다. * 단, carbapenemase 생산균(MBL 등)에는 효과 없습니다. |
| 💊 Ceftolozane-tazobactam (세프톨로잔-타조박탐) |
| 신규 개발된 cephalosporin + β-lactamase inhibitor 조합으로, 다제내성 녹농균(MDR-PA)에 대해서도 활성을 가집니다. 복합성 요로감염, 복강 내 감염에 적응. |
| 💊 Ceftazidime-avibactam (세프타지딤-아비박탐) |
| 3세대 세팔로스포린과 강력한 β-lactamase 억제제 조합으로, carbapenemase가 아닌 AmpC, ESBL, KPC 보유 균주에 효과적입니다. |
| 💊 Polymyxin B / Colistin (폴리믹신 B / 콜리스틴) |
| 막을 파괴하는 기전을 가지며, 다른 약물에 모두 내성일 때 최후의 수단으로 사용합니다. 신독성/신경독성 위험이 큽니다. |
| 💊 Gentamicin, Tobramycin, Amikacin (아미노글리코사이드계) |
| 단독보다는 β-lactam 항생제와 병용하여 사용하며, 세포 내 단백질 합성 억제를 통해 살균 작용을 보입니다. 신독성/이독성 유의. |
| 💊 Ciprofloxacin, Levofloxacin (퀴놀론계) |
| Ciprofloxacin은 녹농균에 대해 가장 강력한 fluoroquinolone이며, levofloxacin도 어느 정도 활성 보입니다. 다만 내성 증가 추세에 유의해야 합니다. |
예후
면역저하자에서는 감염이 급속히 진행될 수 있으며, 치료가 지연되면 치명적일 수 있습니다.
| 예후 |
| ✅ 초기 항생제 선택이 적절하면 대부분 완치 가능합니다. |
| ✅ 면역저하자, 중환자에서는 패혈증으로 진행할 수 있으므로 조기 진단이 중요합니다. |
생활 관리
감염 예방을 위해 병원 기기 관리와 위생 유지가 중요합니다.
| 생활 관리 수칙 |
| 🟨 습한 환경 소독 |
| 욕조, 호흡기 기기, 카테터 등은 정기적으로 소독하여 감염원을 차단합니다. |
| 🟨 면역저하자 위생 강화 |
| 장기이식 환자나 항암 치료 중인 환자는 외부 환경에 노출을 최소화하고, 상처는 청결하게 유지해야 합니다. |
